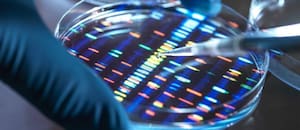
Desafían las leyes de la física y prometen solucionar el problema del almacenamiento masivo de datos

Encontrá las guías de servicio con tips de los expertos sobre cómo actuar frente a problemas cotidianos: Adicciones, violencia, abuso, tecnología, depresión, suicidio, apuestas online, bullying, transtornos de la conducta alimentaria y más.

Una nueva y sólida evidencia sugiere que seguir la dieta mediterránea, al mismo tiempo que se reducen las calorías y se aumenta la actividad física, disminuye el riesgo de desarrollar diabetes tipo 2.
Un gran ensayo aleatorizado en España descubrió que adultos mayores en riesgo de diabetes que siguieron esta dieta, redujeron su ingesta calórica y realizaron ejercicio regularmente, fueron un 31% menos propensos a desarrollar la enfermedad después de seis años, en comparación con quienes solo siguieron la dieta mediterránea. Esta dieta enfatiza el consumo de frutas y verduras frescas, granos integrales, frutos secos, legumbres, aceite de oliva y pescado.
Los hallazgos amplían los resultados de un ensayo anterior relacionado, que mostró que los participantes que simplemente siguieron una dieta mediterránea eran un 30% menos propensos a desarrollar diabetes que aquellos que siguieron solo una dieta baja en grasas. En ese estudio, los participantes no restringieron calorías, no aumentaron la actividad física ni perdieron peso.
El estudio, publicado el lunes en The Annals of Internal Medicine, se suma a un amplio cuerpo de investigación que demuestra que los patrones alimentarios, la actividad física y la pérdida de peso pueden reducir el riesgo de diabetes y otras enfermedades crónicas.
“Confirma mucho de lo que ya sabemos”, dijo Elizabeth Selvin, profesora de epidemiología en la Escuela de Salud Pública Bloomberg de Johns Hopkins.
La dieta y la actividad física “son algunos de los factores de riesgo más importantes para enfermedades cardiovasculares y diabetes”, explicó Selvin, pero son difíciles de estudiar. Este tipo de ensayo aleatorizado de gran escala con intervenciones dietéticas y conductuales, realizado a lo largo de varios años, es difícil pero fundamental, agregó.
Eso se debe a que los ensayos aleatorizados ofrecen la evidencia más sólida de que una intervención específica —y no otro factor— está causando la diferencia en los resultados observados entre dos grupos.
El papel de la dieta, el ejercicio y la pérdida de peso en la reducción del riesgo de diabetes fue establecido en un ensayo histórico del Diabetes Prevention Program en 2002. Los pacientes asignados aleatoriamente a recibir educación, hacer ejercicio al menos 150 minutos por semana y seguir una dieta baja en calorías y grasas para reducir su peso en un 7% vieron una reducción del 58% en su riesgo de diabetes, en comparación con el grupo placebo.

La investigación de la Dra. Selvin, publicada este mes en Nature Medicine, encontró que una dieta DASH modificada rica en frutas, verduras y productos lácteos bajos en grasa ayudó a pacientes con diabetes a reducir su nivel promedio de glucosa en sangre. También aumentaron el tiempo que pasaban dentro del rango recomendado.
Otro estudio, publicado el lunes en Nature Medicine, descubrió que la dieta mediterránea se asoció con menores probabilidades de desarrollar Alzheimer entre personas con alto riesgo genético.
El ensayo español siguió a casi 5000 adultos de entre 55 y 75 años con sobrepeso u obesidad y síndrome metabólico, pero sin antecedentes de enfermedad cardiovascular ni diabetes al inicio.
El síndrome metabólico es un conjunto de afecciones —como grasa abdominal, glucemia alta y presión arterial elevada— que aumentan el riesgo de desarrollar diabetes y otras enfermedades crónicas.
Quienes estuvieron en el grupo de intervención se reunieron con un nutricionista regularmente durante seis años y recibieron asesoramiento sobre cómo seguir la dieta mediterránea y reducir calorías. También se les recomendó adoptar un programa de ejercicios de 45 minutos al día, seis veces por semana, de caminata rápida o actividad aeróbica equivalente, además de entrenamiento de fuerza y equilibrio dos a tres veces por semana. El grupo de control solo recibió educación sobre la dieta mediterránea y tuvo encuentros menos frecuentes con nutricionistas. Todos los participantes recibieron aceite de oliva, un componente costoso de la dieta.

El grupo de intervención perdió más de tres kilos después de seis años y redujo su circunferencia de cintura en 3,5 cm, en promedio, comparado con apenas medio kilo y 0,2 cm en el grupo de control. La cantidad de peso perdido representó el 3,7% del peso corporal, menos de lo que se suele considerar necesario para reducir la incidencia de diabetes.
“La buena noticia es que incluso un cambio modesto impactó en el riesgo”, dijo Miguel Ángel Martínez-González, profesor de salud pública en la Universidad de Navarra e investigador del ensayo.
La reducción relativa del 31% en el riesgo de diabetes significó, esencialmente, que las medidas en el grupo de intervención llevarían a aproximadamente tres casos menos de diabetes por cada 100 personas.
“No tenemos forma de aislar cuál fue el factor clave aquí”, dijo la Dra. Tirissa J. Reid, profesora asociada de medicina en el Columbia University Irving Medical Center, quien no participó en el ensayo. Pero está bien establecido que la pérdida de peso marca una diferencia en la reducción del riesgo de diabetes, y probablemente fue un factor importante, agregó.
Según Reid, mucho antes de que se manifieste la diabetes tipo 2 o la prediabetes, los pacientes comúnmente desarrollan resistencia a la insulina, una condición en la cual el cuerpo no responde bien a la insulina. La actividad física, las dietas ricas en fibra como la mediterránea, y la pérdida de peso pueden reducir esa resistencia.
La dieta, el ejercicio y la pérdida de peso también podrían reducir la inflamación y el estrés oxidativo, un proceso que daña las células, explicaron los investigadores. En conjunto, estos beneficios pueden reducir el riesgo de diabetes.
“Es como una orquesta”, dijo el Dr. Jordi Salas Salvadó, profesor de nutrición en la Universitat Rovira i Virgili, en España, y autor principal del estudio. “Un instrumento suena bien, pero cuando varios instrumentos tocan al mismo tiempo, la melodía mejora”.
Un aspecto destacado del ensayo, señaló Nicole Patience, nutricionista del Joslin Diabetes Center en Boston (no involucrada en el estudio), fue la intensidad del apoyo y la educación.
Seis años es “mucho tiempo para ayudar a las personas a mantener sus intenciones” y lograr un cambio conductual duradero, comentó. Los participantes del grupo de tratamiento tuvieron contacto regular y frecuente con un nutricionista, mientras que el grupo de control no recibió el mismo nivel de orientación.
No está claro cuánto del efecto se debió al apoyo versus la intervención dietética y física en sí misma.
En el mundo real, replicar ese nivel de contacto podría ser difícil. Y la dieta mediterránea puede no ser adecuada para todos.
Aun así, concluyó Patience, este estudio demuestra que realizar pequeños ajustes en la dieta y sumar ejercicio puede generar un gran impacto en la salud a largo plazo.